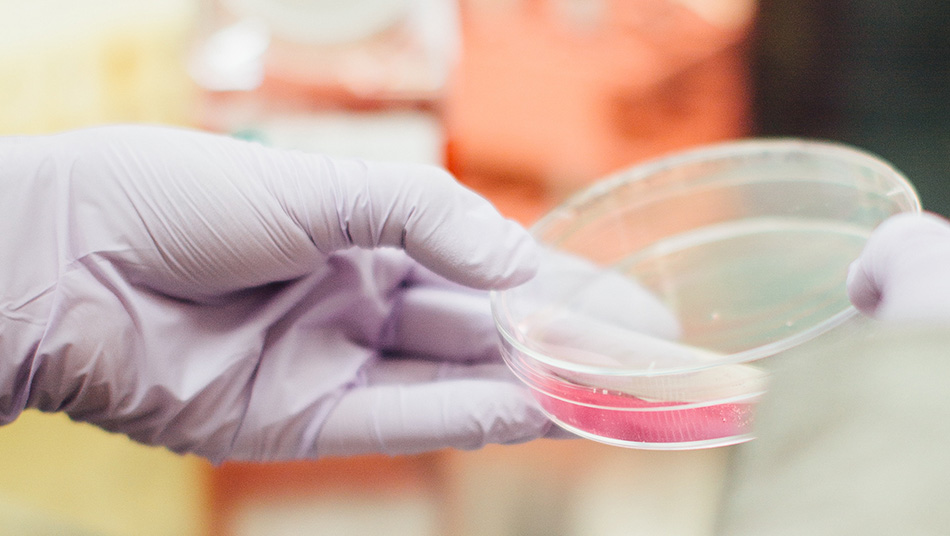

Noticias
Descubren cómo las células tumorales imitan a las vasculares en los cánceres más agresivos
10/06/2019
Las células tumorales con alta agresividad son capaces de adquirir características de células vasculares (endoteliales) para de esta manera “imitar” una red de vasos en el interior de un tumor de manera que pueden aportar nutrientes y oxígeno en ausencia de vasos sanguíneos. Para estudiar este proceso y sus transformaciones básicas, investigadores del CIBER de Cáncer (CIBERONC), dirigidos por Javier Oliver, han realizado un trabajo que ha sido publicado en Cell Death and Differentiation, en el que se aborda la siguiente pregunta: ¿qué transformaciones básicas pueden convertir a una célula metastásica en una ‘falsa célula endotelial’?.
Fuente: Jano











